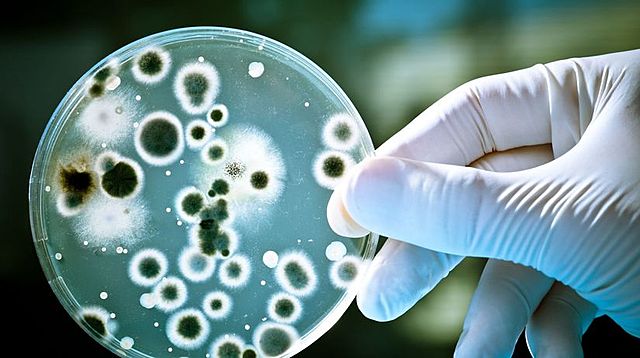
Vynájdenie penicilínu

-
7.marca 1872 sa v holadskom meste Amersfoort narodil Pieter Cornelis Mondriaan
-
1876 - americký fyzik Alexander Graham Bell prvý raz komunikoval pomocou svojho nového vynálezu – telefónu
-
1879 - Marcelino de Sautuola objavil jaskyňu Altamira s nádhernými maľbami paleolitického človeka
-
1880 – Karl Benz vynašiel prvý automobil poháňaný spaľovacím motorom
-
1886 - v New Yorku bola verejnosti sprístupnená Socha Slobody.
Socha je vysoká 46 metrov a váži necelých 205 ton. Spolu so 47-metrovým podstavcom je vrchol fakle vo výške 93 metrov nad zemou.
Socha získala svoju charakteristickú zelenkastú farbu až po roku 1900 vplyvom oxidácie. Pôvodne bola vo farbe medi. -
1887 - začiatok stavby Eiffelovej veže.
Táto 324 metrov vysoká a 10 100 ton vážiaca architektonická dominanta bola uvedená do prevádzky v roku 1889 ako symbol Svetovej výstavy a hneď sa stala atrakciou hlavného mesta. -
1892 – zač.študovať na Akadémii umení v Amsterdame
-
1895 – začína sa venovať krajinomaľbe
-
1899 – dostal sa k teozofii, ktorej myšlienky na neskôr odrážali v jeho tvorbe
-
1900 – Svetová výstava v Paríži - V Paríži sa koná Svetová výstava, na ktorej sa oslavujú úspechy rôznych krajín a vystavujú najnovšie vynálezy, ako sú dieselový motor, zvukový film a eskalátory. Navštívilo ju viac než 50 miliónov ľudí.
-
1901 – objavené základné krvné skupiny
Objav krvných skupín AB0 sa všeobecne pripisuje viedenskému vedcovi Karlovi Landsteinerovi, ktorý v roku 1901 objavil tri krvné skupiny A, B a C (dnešné A, B a 0). Za tento objav dostal v roku 1930 Nobelovu cenu za fyziológiu alebo medicínu. V roku 1921 ale americká lekárska komisia dala prednosť Janskému, ktorý síce krvné skupiny objavil neskôr, ale na rozdiel od Landsteinera všetky 4. -
1903 – pobyt v Brabante v Holandsku, kde maľuje prevažne osamelé domy a využíva najmä mdlé sivé odtiene
-
1908 – prvý raz použitý pojem kubizmus francúzskym kritikom. V tom čase bolo toto označenie myslené hanlivo.
Kubizmus bolo avantgardné umelecké hnutie, ktoré pripomína výtvarné umenie revolučným spôsobom. Princíp kubizmu spočíva v jeho priestorovej koncepcii diela, predmet nezobrazuje len z jedného uhla, ale z mnohých uhlov súčasne. Najvýznamnejší predstavitelia kubisti Georges Braque a Pablo Picasso. -
1909 – vychádza manifest futurizmu
-
1911 – prichádza do Paríža, kde si mení meno na Piet Mondrian, je tu ovplyvnený kubizmom. V jeho dielach prevažuje rytmus, línie a základné farby
-
Zámienkou vojny sa stal úspešný atentát na arcivojvodu a následníka rakúsko-uhorského trónu Františka Ferdinanda d'Este. Rakúsko-Uhorsko následne vyhlásilo vojnu Srbsku, čím vyvolalo reťazovú reakciu vedúcu k vojne dvoch veľkých koalícií, ktoré mali za následok rozšírenie vojny po celej Európe v priebehu jediného mesiaca.
-
-
De Stijl je jedna z avantgardných skupín, ktorá výrazne ovplyvnila vývoj modernej architektúry v Európe.
-
1917 – 1.číslo De Stijl – vychádza v ňom Mondiranova esej, ktorú možno zaradiť medzi základné kamene abstraktného umenia
-
1918 - Škótsky lekár a bakteriológ Alexander Fleming náhodou objavuje antibiotikum penicilín. O takmer 15 rokov neskôr toto antibiotikum zachraňuje prvého pacienta.
-
Program Bauhausu vyhlásený manifestom W. Gropiusa.
Staatliches Bauhaus (doslova "štátny stavebný dom") alebo skrátene Bauhaus bola nemecká vysoká škola, v ktorej bola skombinovaná výuka umeleckej tvorby s výukou remesiel. Škola bola prevádzkovaná v rokoch 1919 až 1933 vo Weimare, neskôr v Dessau a posledný rok svojej existencie v Berlíne. Bauhaus výrazne ovplyvnil modernú architektúru a moderný dizajn. -
Versaillská (mierová) zmluva bola mierová zmluva uzatvorená vo Versailles 28. júna 1919 a vstúpila do platnosti 10. januára 1920. Bola výsledkom šesťmesačného rokovania na Parížskej mierovej konferencii, ktorá oficiálne ukončila prvú svetovú vojnu medzi Ústrednými veľmocami a štátmi Dohody.
-
-
1920 – prvé zasadnutie Spoločnosti národov v Ženeve
-
1922 – začína obdobie jeho ústrednej tvorby, kedy maľuje prevažne na štvorcové plátna a využíva biele pozadie, čierne línie a na mnohých možno nájsť veľký červený obdlžnik typický pre jeho tvorbu, ktorý zaberá aj 2/3 plána
-
1923 – v Taliansku za vlády Benita Mussolinihovznikajú dobrovoľné fašistické milície
-
1925 – Bauhaus vydáva jeho Neue Gestantung – preklad diela Neoplasticizmus
-
1926 – jeho dielo bolo prvý raz uvedené v NY
-
-
-
-
1938 – kedže sa blíži vojna, odchádza do Londýna v domnení, že Paríž nebude bezpečné miesto
-
-
sťahuje sa do NY, tam úplne vynecháva čiernu farbu v maľbe
-
-
Looking for a timeline maker?
Create timelines for projects, roadmaps, history, lessons, legal cases, and stories with Timetoast. Timetoast is a timeline maker for work, school, research, and stories.